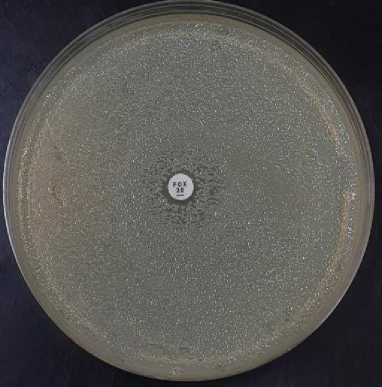

DETECTION OF METHICILLIN-SENSITIVE STAPHYLOCOCCUS AUREUS AND METHICILLIN-RESISTANT STAPHYLOCOCCUS AUREUS IN THE INTENSIVE CARE UNIT OF PURI RAHARJA HOSPITAL
on
ISSN: 2597-8012 JURNAL MEDIKA UDAYANA, VOL. 10 NO.12,DESEMBER, 2021

Diterima: 2020-12-11 Revisi: 2021-06-30 Accepted: 01-12-2021
DETEKSI METHICILLIN-SENSITIVE STAPHYLOCOCCUS AUREUS DAN METHICILLIN-RESISTANT STAPHYLOCOCCUS AUREUS PADA LINGKUNGAN INTENSIVE CARE UNIT RUMAH SAKIT UMUM PURI RAHARJA
I Made Widianantara1, Ni Nyoman Sri Budayanti2, Ni Nengah Dwi Fatmawati2, Made Agus Hendrayana2 1Program Studi Sarjana Kedokteran dan Profesi Dokter Universitas Udayana 2Departemen Mikrobiologi Klinik Fakultas Kedokteran Universitas Udayana e-mail: widianantaramade@gmail.com
ABSTRAK
Health care-associated infections (HAIs) merupakan infeksi yang disebabkan oleh mikroorganisme yang terdapat di pusat layanan kesehatan. Pasien yang dirawat di Intensive Care Unit (ICU) merupakan populasi yang paling sering terjangkit HAIs. Salah satu mikroorganisme penyebab HAIs yang paling umum adalah bakteri Staphylococcus aureus. Methicillin-resistant Staplylococcus aureus (MRSA) adalah strain dari Staphylococcus aureus yang resisten terhadap antibiotika golongan β-laktam. Kontaminasi Methicillin-sensitive Staphylococcus aureus (MSSA) dan MRSA pada peralatan medis, termasuk di ICU, merupakan salah satu penyebab terjadinya HAIs. Oleh karena itu, diperlukan penelitian untuk menentukan tingkat kontaminasi bakteri tersebut pada peralatan medis dan benda-benda pada ruang perawatan. Penelitian ini bertujuan untuk mendeteksi MSSA dan MRSA pada lingkungan ICU Rumah Sakit Umum (RSU) Puri Raharja. Jenis penelitian ini adalah penelitian deskriptif dengan rancangan penelitian observasional. Populasi penelitian adalah benda yang berada di lingkungan RSU Puri Raharja. Sampel pada penelitian ini adalah permukaan benda yang ada pada ruangan ICU RSU Puri Raharja berupa bed rail, meja, gorden, gagang pintu, dan stetoskop yang memenuhi kriteria penelitian. Jumlah sampel pada penelitian ini adalah 30 sampel yang dipilih dengan teknik total sampling. Sampel kemudian diambil menggunakan lidi kapas steril kemudian diinokulasikan pada Staphylococcus medium. Koloni yang terbentuk kemudian diuji biokimia dengan uji katalase dan koagulase untuk identifikasi S. aureus. Uji skrining cefoxitin kemudian dilakukan dengan cefoxitin disk diffusion test dan didapatkan 1 dari 30 (3,33%) sampel menunjukkan hasil MRSA positif. Penelitian ini menunjukkan terdapat kontaminasi MRSA pada satu bed rails ICU RSU Puri Raharja.
Kata kunci : Methicillin-resistant staphylococcus aureus, Intensive care unit, Health care-associated infections
ABSTRACT
Health care-associated infections (HAIs) are infections caused by microorganisms found in health care centers. Intensive Care Unit (ICU) patients are the population that most frequently infected with HAIs. One of the most common microorganisms that cause HAIs is Staphylococcus aureus. Methicillin-resistant Staplylococcus aureus (MRSA) is a strain of Staphylococcus aureus that is resistant to β-lactam. Methicillin-sensitive Staphylococcus aureus (MSSA) and MRSA that contaminate medical equipments, including in the ICU, are the causes of HAIs. Therefore, research must be done to determine the levels of bacterial contamination on medical equipments and objects in the hospital ward. This study aimed to detect MSSA and MRSA in the ICU of Puri Raharja Hospital. This study was a descriptive study with a observational study design. The research population was the environmental surfaces in Puri Raharja Hospital environment. The samples in this study were 30 environmental surfaces in the ICU at Puri Raharja Hospital in the form of bed rails, tables, curtains, door handles, and stethoscopes that met the research criteria. The total number of samples used in this study were thirty that selected by total sampling technique. Samples were taken using sterile cotton swabs and then inoculated on Staphyococcus medium. Colonies were then tested by using catalase and coagulase tests to identify Staphylococcus aureus. Cefoxitin screen test showed that 1 out of 30 (3.33%) samples positive for MRSA. This study shows that there is MRSA contamination in one of the bed rails at Puri Raharja Hospital’s ICU.
Keywords : Methicillin-resistant staphylococcus aureus, Intensive care unit, Health care-associated infections
PENDAHULUAN
Infeksi merupakan proses masuknya mikroorganisme seperti bakteri, virus, maupun parasit yang normalnya tidak terdapat dalam tubuh. Mikroorganisme tersebut dapat memperbanyak diri dan menimbulkan penyakit infeksi dikarenakan adanya kerusakan pada jaringan tubuh. Infeksi dapat terjadi di semua tempat, tidak terkecuali rumah sakit. Penularan infeksi terjadi secara penularan langsung melalui udara dan benda-benda yang ada di rumah sakit. Infeksi yang disebabkan oleh mikroorganisme yang terdapat di rumah sakit disebut sebagai infeksi nosokomial atau healthcare associated infections (HAIs). Infeksi ini dapat terjadi selama seseorang mendapatkan perawatan bahkan hingga masa rawat inap berakhir.1
Pasien yang dirawat di Intensive Care Units (ICU), unit luka bakar, pasien penerima donor organ, dan neonatus merupakan populasi yang paling sering terjangkit HAIs. Peningkatan angka infeksi dapat menyebabkan pemanjangan masa rawat, cacat jangka panjang, peningkatan resistensi antimikroba, gangguan sosial-ekonomi, dan peningkatan angka kematian.2 Salah satu mikroorganisme penyebab HAIs yang paling umum adalah bakteri Staphylococcus aureus.3,4
Staphylococcus aureus merupakan penyebab utama pneumonia dan infeksi pembedahan serta penyebab bakteremia nosokomial.5 Penggunaan antibiotik yang kurang tepat pada era antibiotik modern menyebabkan munculnya strain baru dari bakteri yang salah satunya adalah strain yang resisten terhadap antibiotik.6 Methicillin-resistant Staphylococcus aureus (MRSA) merupakan strain dari Staphylococcus aureus. MRSA menjadi penyebab utama dari HAIs dan dikaitkan dengan peningkatan morbiditas dan mortalitas.7
Terdapat banyak penelitian yang menunjukkan bahwa MRSA dapat mengkontaminasi permukaan dan benda-benda yang terdapat di lingkungan rumah sakit dan dapat menyebar melalui kontak langsung sehingga dapat meningkatkan angka kejadian HAIs.8–15 Sama seperti spesies Staphylococcus aureus lainnya, MRSA dapat hidup dalam jangka waktu yang panjang pada permukaan yang kering, sementara tingkat kontaminasi dapat dipengaruhi oleh higienitas dan kebersihan.16
MRSA dapat hidup di permukaan benda dan membentuk koloni. Penelitian yang dilakukan oleh Coughenour pada tahun 2011 menunjukkan bahwa MRSA dapat hidup di permukaan benda seperti kayu hingga 2 hari, pakaian hingga 4 hari, dan benda yang terbuat dari plastik hingga 5 hari.17 Maka dari itu, permukaan benda merupakan salah satu media atau vektor penyebaran Staphylococcus aureus dan MRSA sebagai penyebab HAIs.8,10 Berdasarkan hal tersebut, penelitian ini bertujuan untuk mendeteksi kontaminasi MSSA dan MRSA pada lingkungan ICU Rumah Sakit Umum (RSU) Puri Raharja.
BAHAN DAN METODE
Jenis penelitian yang digunakan dalam penelitian ini adalah penelitian observasional deskriptif dengan rancangan penelitian cross sectional. Pengambilan sampel dilakukan di ruang ICU RSU Puri Raharja, Denpasar. Populasi target adalah benda-benda pada ICU di seluruh rumah sakit. Populasi terjangkau dari penelitian ini adalah benda-benda yang ada di lingkungan ruang ICU RSU Puri Raharja. Sampel yang diambil adalah benda-benda yang kontak dengan pasien serta tenaga kesehatan yaitu bed rail, meja, gorden, gagang pintu, dan stetoskop. Uji identifikasi dan skrining cefoxitin dilakukan di Laboratorium Mikrobiologi Fakultas Kedokteran Universitas Udayana. Kriteria sampel adalah benda-benda yang berada di dalam lingkungan ICU RSU Puri Raharja.
Sampel swab diambil menggunakan lidi kapas steril kemudian dilakukan striking pada plat Staphylococcus medium no. 110 lalu diinkubasi selama 24-48 jam. Pada sampel yang menunjukkan pertumbuhan koloni dilanjutkan dengan melakukan subkultur untuk mendapatkan koloni tunggal. Koloni tunggal yang terbentuk kemudian diuji katalase menggunakan Hidrogen Peroksida (H2O2) 3%. Sampel yang menunjukkan buih pada H2O2 yang ditambahkan koloni bakteri diintepretasikan sebagai uji katalase positif. Uji koagulase dilakukan menggunakan Staphaurex* Latex Agglutination Test kit. Sampel yang menunjukkan penggumpalan pada saat koloni bakteri dicampurkan dengan reagen diinterpretasikan sebagai uji koagulase positif. Hasil uji katalase dan koagulase positif digolongkan sebagai Staphylococcus aureus.
Sampel yang menunjukkan pertumbuhan koloni Staphylococcus aureus lalu diuji sensitivitasnya terhadap cefoxitin menggunakan cefoxitin disk diffusion test. Sebanyak beberapa koloni yang terbentuk diambil lalu disuspensikan dengan NaCl 0,9% hingga kekeruhannya setara dengan standar McFarland 0,5. Suspensi kemudian dioleskan pada Mueller Hinton Agar (MHA) lalu ditempelkan cakram cefoxitin 30µg selanjutnya diinkubasi selama 24 jam.
Zona hambat yang terbentuk pada MHA kemudian diukur menggunakan jangka sorong. Sampel yang menunjukkan zona hambat ≤ 19mm yang berarti resisten terhadap cefoxitin atau MRSA sedangkan sampel yang menunjukkan zona hambat > 20mm sensitif terhadap cefoxitin atau MSSA.
HASIL
Berdasarkan kriteria yang ditetapkan, didapatkan 30 sampel yang memenuhi kriteria penelitian yang terdiri atas 12 sampel bed rails, 6 sampel gorden, 6 sampel meja, 4 sampel stetoskop, dan 2 sampel gagang pintu.
Hasil kultur pada 20 dari 30 sampel menunjukkan pertumbuhan koloni bakteri yang selanjutnya dilakukan uji katalase. Sebanyak 19 sampel menunjukkan hasil uji katalase positif dan 1 uji katalase negatif. Uji koagulase kemudian dilakukan pada 19 sampel katalase positif dan didapatkan 1 dari 19 sampel menunjukkan hasil uji koagulase positif.
Penelitian ini mendapatkan bahwa 1 sampel teridentifikasi positif Staphylococcus aureus yang berasal dari sampel bed rails. Sedangkan, 18 sampel lainnya teridentifikasi sebagai coagulase negative staphylococci (CoNS).
Skrining cefoxitin terhadap sampel yang teridentifikasi sebagai Staphylococcus aureus menunjukkan zona hambat sebesar 7,5mm yang dapat digolongkan sebagai MRSA.
Gambar 1. Hasil uji skrining cefoxitin pada mueller hinton agar
Tabel 1. Distribusi isolat bakteri dari peralatan di ruang ICU RSU Puri Raharja
|
Peralatan |
Interpretasi | ||
|
MSSA |
MRSA |
CoNS | |
|
Bed rail |
0 (0%) |
1 (5,26%) |
8 (42,11%) |
|
Gorden |
0 (0%) |
0 (0%) |
5 (26,32%) |
|
Meja |
0 (0%) |
0 (0%) |
3 (15,79%) |
|
Stetoskop |
0 (0%) |
0 (0%) |
1 (5,26%) |
|
Gagang pintu |
0 (0%) |
0 (0%) |
1 (5,26%) |
|
Total |
0 (0%) |
1 (5,26%) |
18 (94,74%) |
PEMBAHASAN
Prevalensi kolonisasi Staphylococcus aureus pada sampel benda-benda yang ada di ruang Intensive Care Unit RSU Puri Raharja pada penelitian ini adalah sebesar 3,3%. Ditemukan sebanyak 1 sampel yang menunjukkan hasil positif Staphylococcus aureus dari total 30 sampel swab lingkungan yang diperiksa. Bed rails merupakan benda dengan persentase tertinggi dari kolonisasi Staphylococcus aureus. Hal yang sama juga ditunjukkan oleh penelitian yang dilakukan oleh Kurashige et al. pada tahun 2016 di Yamaguchi University Hospital.10 Penelitian tersebut menyatakan bahwa bed rails menjadi benda dengan tingkat kontaminasi tertinggi dari sampel yang diperiksa, dimana dari 19 sampel bed rails yang diperiksa, 6 sampel menunjukkan hasil MRSA positif. Penelitian yang dilakukan oleh Gavaldà et al. pada ruang ICU di Bellvitge Hospital juga menunjukkan hasil yang sama. Bed rails yang termasuk permukaan benda yang ada pada zona pasien dan dapat kontak langsung dengan pasien memiliki tingkat
persentase tertinggi kontaminasi bakteri salah satunya MRSA (53,8%).18
Berbeda dengan penelitian sebelumnya yang dilakukan oleh Darmawi et al. yang menggunakan mannitol salt agar (MSA) dan Kurashige et al. yang menggunakan salt egg yolk agar sebagai media kultur, penelitian ini menggunakan Staphylococcus medium no. 110 sebagai media kultur.10,19 Staphylococcus medium no. 110 merupakan medium selektif yang digunakan untuk isolasi dan diferensiasi Staphylococcus yang bersifat patogenik.20 Didapatkan 20 dari 30 sampel pada penelitian ini yang menunjukkan pertumbuhan koloni bakteri. Setelah dilakukan isolasi, dilakukan uji katalase dengan menggunakan hidrogen peroksida (H2O2) 3% pada 20 sampel yang menunjukkan pertumbuhan koloni, dimana 19 sampel menunjukkan hasil uji katalase yang positif yaitu terdapat buih pada saat koloni bakteri dikenai hidrogen peroksida 3%. Pada sampel yang menunjukkan hasil uji katalase yang positif, dilakukan uji koagulase. Didapatkan 1 dari 19 sampel yang diuji menunjukkan hasil uji koagulase positif yaitu terbentuk koagulasi pada saat koloni bakteri dicampurkan dengan reagen. Uji koagulase dilakukan dengan menggunakan Staphaurex* Latex Agglutination Test kit. Alat diagnostik ini memiliki tingkat sensitivitas sebesar 99,8% serta tingkat spesifisitas sebesar 99,5%.21
Uji skrining cefoxitin kemudian dilakukan untuk mengetahui apakah koloni Staphylococcus aureus yang didapat merupakan Methicillin-sensitive Staphylococcus aureus (MSSA) atau Methicillin-resistant Staphylococcus aureus. Skrining cefoxitin yang dilakukan pada penelitian ini adalah cefoxitin disk diffusion test dimana digunakan cakram cefoxitin 30µg. Terdapat banyak metode yang dapat dilakukan untuk menguji sensitivitas bakteri Staphylococcus aureus terhadap antibiotik golongan β-laktam. Identifikasi gen mecA menggunakan PCR (Polymerase Chain Reaction) merupakan gold standard, namun tidak semua fasilitas laboratorium dapat melakukan PCR serta uji ini memerlukan banyak biaya dan memakan waktu. Penelitian yang dilakukan Rostami et al. menyatakan bahwa cefoxitin disk diffusion test memiliki tingkat sensitivitas dan spesifisitas 100% jika dibandingkan dengan PCR.22
Setelah dilakukan skrining cefoxitin, didapatkan hasil sampel yang diuji sebanyak 1 (satu) sampel menunjukkan zona hambat sebesar 7,5mm yang berarti resisten terhadap cefoxitin atau sampel positif MRSA. Penelitian yang dilakukan Mahmudah et al. menggunakan uji sensitivitas yang sama menunjukkan sampel positif MRSA terbanyak berasal dari ruang ICU.23 Penelitian lain oleh Gavaldà et al. menunjukkan MRSA merupakan bakteri yang paling banyak ditemukan pada area yang sering disentuh oleh pasien maupun tenaga kesehatan pada ruang ICU.18
Pada penelitian ini juga didapatkan terdapat 18 dari 30 (60%) sampel yang menunjukkan hasil uji katalase positif dan uji koagulase negatif. Sampel yang menunjukkan hasil tersebut digolongkan sebagai coagulase negative staphylococci atau CoNS. Semua jenis benda pada
penelitian ini yaitu menunjukkan adanya kontaminasi CoNS. Penelitian Ulger et al. menyatakan bahwa CoNS menjadi bakteri kedua terbanyak (16,67%) setelah Staphylococcus aureus (22,81%) yang ditemukan pada telepon genggam tenaga kesehatan.24 Penelitian yang dilakukan Berlak et al. di Neonatal Intensive Care Unit (NICU) menunjukkan CoNS sebagai penyebab terbanyak (52,3%) late onset sepsis.25
Pada penelitian ini didapatkan sampel positif MRSA sebanyak 1 dari 30 (3,33%) total sampel yang diambil. Hasil ini menunjukkan prevalensi yang lebih rendah dibandingkan penelitian yang dilakukan oleh Asri et al. pada stetoskop di RSUP Dr. M. Djamil Padang pada tahun 2014 yang melaporkan sampel positif MRSA sebanyak 30 dari 74 (40,54%) total sampel yang diambil.26 Penelitian lain yang dilakukan oleh Erlin et al. pada benda-benda di ruang perawatan seperti meja, gunting, dan tiang infus menunjukkan hasil sampel positif MRSA sebanyak 31 dari 40 (77%) koloni Staphylococcus aureus yang diuji
kepekaan terhadap methicillin.27
Pada penelitian ini ditemukan 1 dari 30 (3,33%) sampel menunjukkan hasill MRSA positif. Sampel yang menunjukkan hasil MRSA positif merupakan sampel yang diambil dari bed rails. Penelitian ini juga mendapatkan bahwa 18 sampel yang diperiksa menunjukkan kolonisasi CoNS Penelitian ini memiliki kelemahan, yaitu jumlah sampel penelitian yang masih terbatas.
SIMPULAN DAN SARAN
Terdapat MRSA pada satu bed rails di ICU RSU Puri Raharja. Perlu dilakukannya penelitian lebih lanjut dengan menggunakan sampel lingkungan yang lebih besar dan penelitian pada ruangan perawatan serta rumah sakit lainnya. Perlu juga dilakukan screening pada tenaga kesehatan karena MRSA dapat ditemukan pada manusia dan dapat menyebar melalui kontak langsung. Temuan pada penelitian ini juga mengindikasikan tingkat kebersihan yang masih kurang baik, sehingga harus dilakukan pembersihan atau general cleaning pada semua bed pada lingkungan ruang ICU rumah sakit. Penelitian lebih lanjut juga dapat dilakukan untuk menilai kontaminasi pada peralatan-peralatan lain serta pada udara di ruangan ICU.
DAFTAR PUSTAKA
-
1. Centers for Disease Control and Prevention. Guidelines for environmental infection control in health-care
facilities. Recommendations of CDC and the Healthcare Infection Control Practices Advisory Committee
(HICPAC). 2019; 1(1):1-235.
-
2. Allegranzi B, Nejad SB, Graafmans W, Donaldson L, Attar H, Pittet D, Combescure C. Burden of endemic health-care-associated infection in developing countries: systematic review and meta-analysis. The Lancet. 2011 Jan 15;377(9761):228-41.
-
3. Kos VN, Desjardins CA, Cerqueira G, Van Tonder A, Godfrey P, Griggs A, Palmer KL, Bodi K, Mongodin EF, Holden MT,Wortman J. Comparative genomics of vancomycin-resistant Staphylococcus aureus strains and their positions within the clade most commonly associated with Methicillin-resistant S. aureus hospital-acquired infection in the United States. MBio. 2012 Jul 2;3(3).
-
4. Haque M, McKimm J, Sartelli M, Bakar MA. Health care-associated infections–an overview. Infection and drug resistance. 2018;11:2321.
-
5. Magill SS, Cohen J, Kay R, Bailey C, Boland B, Hellinger W, Carey D, Dominguez K, Edwards J, de Guzman J, Goraczewski L. Prevalence of healthcare-associated infections in acute care hospitals in Jacksonville, Florida. Infection control and hospital epidemiology. 2012 Mar;33(3):283.
-
6. McGuinness WA, DeLeo FR, Malachowa N. Focus: infectious diseases: vancomycin resistance in
Staphylococcus aureus. The Yale journal of biology and medicine. 2017 Jun;90(2):269.
-
7. Dantes R, Mu Y, Petit S, Belflower R, Aragon D, Harrison LH, Lessa FC, Lynfield R, Dumyati G, Nadle J, Ray SM. National burden of invasive methicillin-resistant Staphylococcus aureus infections, United States, 2011. JAMA internal medicine. 2013 Nov 25;173(21):1970-8.
-
8. Weber DJ, Rutala WA, Anderson D. The role of the surface environment in healthcare-associated infections. Current opinion in infectious diseases. 2013 Aug 1;26(4):338-44.
-
9. Shek K, Patidar R, Liu S, Logsetty S, Gawaziuk JP, Gawthrop M, Kohja Z, Kumar A. Rate of contamination of hospital privacy curtains in a burns/plastic ward: A longitudinal study. American Journal of Infection Control. 2018 Sep 1;46(9):1019-21.
-
10. Kurashige E, Furukawa H, Oie S. Contamination of environmental surfaces by methicillin-resistant Staphylococcus aureus (MRSA) in rooms of inpatients with MRSA-positive body sites. brazilian journal of microbiology. 2016 Sep;47(3):703-5.
-
11. Wiener-Well Y, Galuty M, Yinnon AM, Rudensky B, Schlesinger Y, Attias D. Nursing and physician attire as possible source of nosocomial infections. American journal of infection control. 2011 Sep 1;39(7):555-9.
-
12. Munoz-Price LS, Jimenez A, Arheart KL, Mills JP, Fajardo-Aquino Y, Cleary T, DePascale D, Coro G, Birnbach DJ, Lubarsky DA. Associations between bacterial contamination of health care workers' hands and contamination of white coats and scrubs. American journal of infection control. 2012 Nov 1;40(9):e245-8.
-
13. Burden M, Weed D, Cervantes L, Keniston A, Price CS, Albert RK. Newly cleaned physician uniforms and infrequently washed white coats have similar rates of bacterial contamination after an 8‐ hour workday: A randomized controlled trial. Journal of Hospital Medicine. 2011 Apr;6(4):177-82.
-
14. Mediavilla JR, Mathema B, Chen L, Kreiswirth BN. Global epidemiology of community-associated methicillin resistant Staphylococcus aureus (CA-MRSA). Current opinion in microbiology. 2012 Oct 1;15(5):588-95.
-
15. Livorsi DJ, Batteiger B, Arif S, Garry P, Satola SW, Davis TH, Kressel AB, Kundu MG. The Methicillin-resistant Staphylococcus aureus (MRSA) Nasal Realtime PCR: A Predictive Tool for Contamination of the Hospital Environment. Infection control and hospital epidemiology. 2015 Jan;36(1):34.
-
16. Russotto V, Raineri SM, Cortegiani A, Giarratano A. Bacterial contamination of inanimate surfaces and equipment in the intensive care unit. Journal of intensive care. 2015 Dec 1;3(1):54.
-
17. Coughenour C, Stetzenbach LD, Stevens V. An evaluation of methicillin-resistant Staphylococcus aureus survival on five environmental surfaces. Microbial drug resistance. 2011 Aug 1;17(3):457-61.
-
18. Gavaldà L, Dominguez MA, Pequeño S, Soriano A. Environmental contamination by multidrug-resistant microorganisms after daily cleaning. American Journal of Infection Control. 2015 Jul 1;43(7):776-8.
-
19. Darmawi D, Syafruddin S, Zahra AF, Salim MN, Dewi M, Abrar M, Adam M. 6. Isolation, Identification and Sensitivity Test of Staphylococcus aureus on Post Surgery Wound of Local Dogs (Canis familiaris). Jurnal Medika Veterinaria. 2019 Feb 11;13(1):37-46.
. ThermoFisher Scientific. Microbiology Products US Catalog. 2018 Apr;1–288. Available from:
http://tools.thermofisher.com/content/sfs/brochures/US Catalog_EN.pdf
. Oxoid. Staphaurex * [Internet]. United Kingdom; 2011. Available from: https://www.thermofisher.com/
. Rostami S, Torabipour M, Moosavian M, Shoja S, Farshadzadeh Z. Comparison of mecA gene-based PCR with CLSI cefoxitin and oxacillin disc diffusion methods for detecting methicillin resistance in Staphylococcus aureus clinical isolates. African Journal of Microbiology Research. 2013 May 21;7(21):2438-41.
. Mahmudah R, Ekowati CN, Soleha TU. Identifikasi Methicillin-Resistant Staphylococcus Aureus (Mrsa)
Pada Tenaga Medis Dan Paramedis Di Ruang Intensivecare Unit (Icu) Dan Ruang Perawatan Bedah Rumah Sakit Umum Daerah Abdul Moeloek. Jurnal Majority. 2013 Feb 4;2(4).
. Ulger F, Dilek A, Sunbul M, Esen S, Leblebicioglu H. Are healthcare workers’ mobile phones a potential source of nosocomial infections? Review of the literature. The journal of infection in developing countries. 2015 Oct 29;9(10):1046-53.
. Berlak N, Shany E, Chertok IA, Goldinger G, Greenberg D, Ben-Shimol S, Melamed R. Late onset sepsis: comparison between coagulase-negative staphylococci and other bacteria in the neonatal intensive care unit. Infectious Diseases. 2018 Oct 3;50(10):764-70.
. Asri RC, Edison E, Rasyid R. Identifikasi MRSA pada Diafragma Stetoskop di Ruang Rawat Inap dan HCU Bagian Penyakit Dalam. Jurnal Kesehatan Andalas. 2017 Oct 12;6(2):239-44.
. Erlin E, Redjeki S, Rahmat A, Purwianingsih W. Deteksi Methicilin Resistant Staphylococcus aureus (MRSA) Sebagai Penyebab Infeksi Nosokomial Pada Alat-Alat di Ruang Perawatan Bedah. Quagga: Jurnal Pendidikan dan Biologi. 2020 Jul 1;12(2):137-44.
https://ojs.unud.ac.id/index.php/eum
doi:10.24843.MU.2021.V10.i12.P17
104
Discussion and feedback